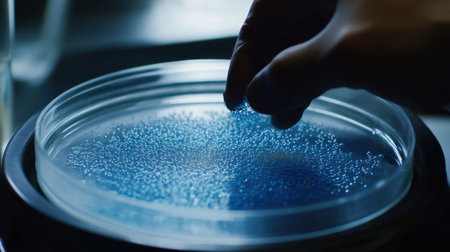
A close-up view of a laboratory hand sampling vibrant blue beads from a petri dish, showcasing the intricate details of scientific research and experimentation.の素材

素材 - A close-up view of a laboratory hand sampling vibrant blue beads from a petri dish, showcasing the intricate details of scientific research and experimentation.
作品情報
A close-up view of a laboratory hand sampling vibrant blue beads from a petri dish, showcasing the intricate details of scientific research and experimentation.
- ID:262745713
- 作品種別:
- 作者名:arthittaya chaiya
キーワード
- aesthetic
- analysis
- beads
- biotechnology
- blue
- chemistry
- close-up
- detail
- development
- dish
- education
- environment
- equipment
- experiment
- exploration
- focus
- formulation
- glassware
- hand
- health
- healthcare
- innovation
- investigation
- laboratory
- liquid
- material
- measurement
- microbiology
- nature
- observation
- petri
- precision
- process
- research
- researcher
- sample
- sampling
- science
- science lab
- scientific
- study
- synthetic
- technique
- technology
- texture
- visual
類似作品
A futuristic sc...
Chemical labora...
Laboratory glas...
Equipment for t...
Blurred backgro...
Microscope in t...
The laboratory ...
Bottling proces...
Modern medical ...
Modern empty bi...
A scientist's b...
This laboratory...
A modern labora...
Scientist pipet...
Laboratory for ...
A modern labora...
Science lab wit...
Modern laborato...
Scientist pipet...
Chemical labora...
A brightly lit,...
illustration of...
A scientific me...
immaculate labo...
cell culture
Laboratory inte...
Concrete testin...
High tech labor...
Chemistry lab l...
Chemical labora...
Obscured backdr...
Brightly colore...
Test tubes with...
chemicals purpl...
A close-up of c...
The laboratory ...
Flask with blue...
test laboratory...
Tests of plants...
Researchers wor...
microscope in l...
Abstract backgr...
Scientists cond...
Well-organized ...
3d printer prin...
Chemical Scient...
Vibrant and bri...
Laboratory glas...
A variety of fl...